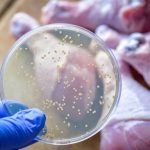

Les Fondements de l’Interaction entre Yoga et Nutrition
Découvrir comment le yoga et la nutrition se complètent ouvre la voie à un bien-être holistique. Le yoga repose sur des principes fondamentaux d’équilibre, de respiration et de conscience corporelle, favorisant la détente et la régulation du système nerveux. Cette pratique ne se limite pas au simple exercice physique : elle vise une harmonie intérieure durable.
Sur le plan alimentaire, adopter une alimentation saine adaptée à la pratique du yoga est essentiel. Il s’agit de privilégier des aliments naturels, riches en nutriments, facilement digestibles pour ne pas perturber l’énergie du corps durant la méditation ou les postures. Les fruits, légumes frais, céréales complètes et légumineuses forment les bases d’un régime nutritif en phase avec les exigences du yoga.
Lire également : Découvrez les bienfaits des huiles de massage pour votre peau
La recherche scientifique souligne plusieurs liens science-santé entre ces deux disciplines. Par exemple, une alimentation équilibrée influence positivement la concentration et la vitalité, éléments indispensables pour tirer pleinement profit du yoga. Inversement, le yoga améliore la digestion et réduit le stress, ce qui optimise l’assimilation des nutriments. Ces points d’interconnexion prouvent que yoga et nutrition ne peuvent être dissociés sans compromettre le bien-être global.
Les Bénéfices de l’Équilibre entre Yoga et Nutrition
Trouver un équilibre énergétique entre le yoga et la nutrition offre des avantages santé yoga nutrition profonds. La pratique régulière du yoga améliore la digestion en stimulant les organes internes et en favorisant une meilleure absorption des nutriments essentiels. Associée à une alimentation équilibrée, cette synergie optimise la vitalité physique et mentale.
Dans le meme genre : Les tisanes bio de la ferme saint sylvain : un pur délice naturel
Les bienfaits physiques et mentaux ressentis incluent une gestion efficace du stress grâce à des exercices de respiration et de méditation, qui complètent l’action apaisante de certains aliments riches en antioxydants et vitamines. Cette association aide à calmer l’esprit, ce qui améliore considérablement la concentration. Par exemple, de nombreux pratiquants rapportent une meilleure capacité à se focaliser au travail après avoir intégré ces deux pratiques dans leur routine.
L’équilibre entre yoga et nutrition favorise aussi une récupération rapide après l’effort, en réduisant les courbatures et en régulant les niveaux d’énergie sur la journée. Cette double approche contribue enfin à un sommeil plus réparateur, essentiel pour le bien-être global. Ainsi, harmoniser yoga et alimentation n’est pas seulement bénéfique, c’est une véritable source de mieux-être durable.
Conseils Pratiques pour Intégrer Yoga et Nutrition au Quotidien
Intégrer le yoga et une bonne nutrition dans votre routine quotidienne demande organisation et constance. Pour démarrer, établissez une routine bien-être combinant des postures de yoga simples avec des exercices de respiration. Par exemple, pratiquer des asanas doux comme la posture de l’enfant ou du guerrier pendant 15 minutes, accompagnées d’une respiration consciente, prépare le corps et l’esprit à la journée.
Concernant l’alimentation, il est conseillé de privilégier des aliments légers et énergétiques avant la séance de yoga, tels que les fruits frais ou une petite poignée de noix. Après la pratique, optez pour des repas riches en protéines végétales, légumes verts, et grains complets afin de favoriser la récupération musculaire et l’équilibre énergétique.
Chaque mode de vie exige des ajustements : un actif pourra intégrer des smoothies protéinés pour soutenir ses efforts, tandis qu’un sédentaire privilégiera des aliments plus digestes et hydratants. Ces conseils pratiques yoga nutrition facilitent une synergie bénéfique entre mouvement et alimentation, en adaptant vos habitudes à vos besoins spécifiques. Ce double focus aide à renforcer vitalité et bien-être global sans complexité inutile.
Exemples de Routines et Plans Alimentaires Appropriés
Il est crucial d’adopter une alimentation adaptée pour accompagner la pratique du yoga, en favorisant une digestion légère et une énergie durable. Avant une séance, privilégiez des repas faciles à digérer, comme un smoothie aux fruits frais, des flocons d’avoine ou une salade légère. Ces choix fournissent une énergie stable sans alourdir le corps.
Après le yoga, il est recommandé de consommer des aliments riches en protéines et en nutriments, tels que des légumes vapeur avec du quinoa, ou du yaourt nature avec des fruits secs. Ces menus aident à la récupération musculaire et maintiennent un bon équilibre énergétique.
Une routine alimentaire associée au yoga peut inclure trois repas équilibrés et deux collations légères, en intégrant des légumes frais, des légumineuses, des céréales complètes et des sources de bonnes graisses. Par exemple, une journée type pourrait commencer par un petit-déjeuner aux graines de chia et fruits, suivi d’une séance matinale, un déjeuner riche en fibres, une collation à base de noix, et un dîner léger.
En combinant ces exemples de menus pour yogis avec une routine régulière de yoga, on maximise les bénéfices sur le corps et l’esprit, tout en respectant les besoins nutritionnels spécifiques.
Conseils d’Experts et Recommandations Fondées
Découvrez comment intégrer harmonieusement yoga et nutrition grâce aux conseils d’experts. Les professeurs de yoga insistent souvent sur l’importance d’une alimentation équilibrée pour maximiser les bienfaits physiques et mentaux de la pratique. Ils recommandent des aliments légers, faciles à digérer, favorisant un esprit clair et un corps souple.
Les nutritionnistes, quant à eux, soulignent que la combinaison de ces pratiques doit être personnalisée. Par exemple, opter pour des repas riches en protéines végétales et en antioxydants aide à la récupération musculaire et réduit l’inflammation. Ces recommandations scientifiques sont appuyées par des études qui montrent comment une alimentation saine améliore la concentration et l’énergie pendant les séances de yoga.
Les témoignages de spécialistes corroborent également ces conseils. Ils encouragent à écouter les sensations du corps, à ajuster son régime selon les besoins spécifiques et à privilégier des aliments naturels pour une meilleure intégration des deux disciplines. Pour approfondir cette synergie, il est conseillé de consulter des travaux académiques et des ateliers combinant nutrition et yoga, garantissant une progression équilibrée et durable.